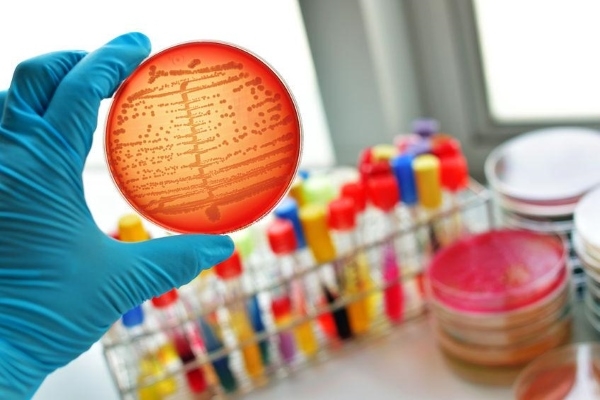
Диагностика стафилококковой инфекции

Стафилококк — группа бактерий, вызывающих инфекции у человека, от легких кожных заболеваний до серьезных системных инфекций. Хотя многие из нас являются носителями этих микроорганизмов, их активизация может привести к опасным последствиям для здоровья. В статье рассмотрим опасности стафилококка, симптомы инфекции и методы лечения. Понимание стафилококковых инфекций поможет читателям своевременно распознать угрозу и обратиться за медицинской помощью, особенно в условиях растущей антибиотикорезистентности.
Причины и способы попадания инфекции
Заражение стафилококковой инфекцией может произойти от человека, который болен или является носителем этой бактерии. Для того чтобы инфекция развилась в организме, необходимо сочетание внедрения бактерий и ослабленного иммунитета. Существует несколько способов, которыми стафилококки могут попасть в организм:
- Воздушно-капельный путь. Бактерии попадают в воздух, который вдыхает человек, когда больной или носитель чихает или кашляет. В закрытых помещениях или многолюдных местах риск заражения значительно увеличивается.
- Контактно-бытовой путь. Инфицирование происходит при использовании общих предметов, таких как полотенца, посуда или постельное белье, с инфицированным человеком.
- Алиментарный путь. Микробы проникают в организм через грязные руки или зараженные продукты питания. Они могут выделяться в окружающую среду с испражнениями или рвотными массами.
- Пылевой путь. Бактерии могут долго сохраняться в пыли как в домашних условиях, так и на улице. При вдыхании пыли они могут вызвать инфекцию.
- Медицинский путь. Инфицирование может произойти через недостаточно стерильные медицинские инструменты во время диагностических процедур или операций.
Новорожденные дети часто заражаются стафилококком в роддоме, где инфекция может передаваться через грудное молоко, смеси или медицинские инструменты.
Факторы, способствующие распространению инфекции:
- ослабленный иммунитет;
- наличие хронических заболеваний;
- частое использование антибиотиков и гормональных препаратов;
- пренебрежение личной гигиеной;
- курение и употребление алкоголя;
- эндокринные расстройства;
- химиотерапия и частые рентгенологические исследования.
Стафилококки представляют собой группу бактерий, способных вызывать широкий спектр инфекций — от легких кожных заболеваний до серьезных системных инфекций. Врачи подчеркивают, что опасность стафилококка заключается в его способности вызывать воспалительные процессы и в возможности появления антибиотикорезистентных штаммов, таких как золотистый стафилококк. Это усложняет лечение и требует индивидуального подхода.
Инфекции, вызванные стафилококками, могут проявляться в виде фурункулов, абсцессов, пневмонии и даже сепсиса. Врачи рекомендуют обращаться за медицинской помощью при первых признаках инфекции. Лечение обычно включает антибиотики, выбор которых зависит от чувствительности бактерий. В некоторых случаях может потребоваться хирургическое вмешательство для удаления гнойных образований. Профилактика включает соблюдение гигиенических норм и укрепление иммунной системы.
Стафилококк представляет собой группу бактерий, которые могут вызывать разнообразные инфекции, от легких кожных заболеваний до серьезных системных инфекций. Эксперты отмечают, что опасность стафилококка заключается в его способности вызывать гнойные воспаления, пневмонию, а также инфекции крови и сердечных клапанов. Особенно рискованными являются штаммы, устойчивые к антибиотикам, такие как MRSA, что усложняет лечение.
Лечение инфекций, вызванных стафилококком, обычно включает антибиотикотерапию, однако выбор препарата зависит от чувствительности конкретного штамма. В некоторых случаях может потребоваться хирургическое вмешательство для удаления гнойных образований. Важно, чтобы пациенты обращались за медицинской помощью при первых симптомах инфекции, так как ранняя диагностика и адекватное лечение значительно повышают шансы на успешное выздоровление. Профилактика также играет ключевую роль: соблюдение гигиенических норм и своевременная вакцинация могут снизить риск заражения.
https://youtube.com/watch?v=ARu6i7bxOWY
Стафилококк представляет собой группу бактерий, которые могут вызывать различные инфекции, начиная от легких кожных заболеваний и заканчивая серьезными системными инфекциями. Эксперты подчеркивают, что опасность стафилококка заключается в его способности вызывать гнойные воспаления, пневмонию и даже сепсис, особенно у людей с ослабленным иммунитетом. Лечение инфекций, вызванных стафилококками, требует комплексного подхода. В большинстве случаев назначаются антибиотики, однако устойчивость некоторых штаммов к лекарствам, таким как метициллин, делает лечение более сложным. Важно также проводить дренирование абсцессов и соблюдать меры профилактики, чтобы избежать повторного заражения. Регулярная гигиена и своевременное обращение к врачу играют ключевую роль в борьбе с этой инфекцией.
Категории риска
Стафилококк может проникнуть в любой организм и вызвать заболевание, но чаще риску подаются:
- грудные дети;
- беременные и кормящие женщины;
- люди с хроническими заболеваниями.
Ослабленный иммунитет, сахарный диабет, применение внутривенных наркотиков, частый прием иммуностимуляторов повышают вероятность заражения стафилококковой инфекцией.
| Аспект | Описание опасности стафилококка | Методы лечения инфекции |
|---|---|---|
| Виды стафилококка | Staphylococcus aureus (золотистый стафилококк): Наиболее опасный, вызывает широкий спектр заболеваний, от кожных инфекций до сепсиса и токсического шока. Часто устойчив к антибиотикам (MRSA). Staphylococcus epidermidis: Чаще вызывает инфекции, связанные с медицинскими имплантатами (катетеры, протезы). Staphylococcus saprophyticus: Основная причина инфекций мочевыводящих путей у молодых женщин. |
Антибиотикотерапия: Выбор антибиотика зависит от вида стафилококка и его чувствительности. Часто используются пенициллины, цефалоспорины, макролиды, линкозамиды, гликопептиды (для MRSA). Дренаж абсцессов: Хирургическое вскрытие и дренирование гнойных очагов. Удаление инфицированных имплантатов: При инфекциях, связанных с медицинскими устройствами. |
| Пути передачи | Контактный: Через прикосновение к инфицированным поверхностям или людям. Воздушно-капельный: При кашле, чихании (реже). Пищевой: Через зараженную пищу (стафилококковый энтеротоксин). Медицинские процедуры: При несоблюдении асептики. |
Гигиена: Регулярное мытье рук с мылом, использование антисептиков. Изоляция: При тяжелых формах инфекции для предотвращения распространения. Санитарная обработка: Дезинфекция поверхностей и инструментов. |
| Опасность для организма | Кожные инфекции: Фурункулы, карбункулы, импетиго, целлюлит. Инфекции дыхательных путей: Пневмония, синусит. Инфекции костей и суставов: Остеомиелит, септический артрит. Инфекции мочевыводящих путей: Цистит, пиелонефрит. Эндокардит: Воспаление внутренней оболочки сердца. Сепсис: Системная воспалительная реакция на инфекцию, угрожающая жизни. Синдром токсического шока: Тяжелое состояние, вызванное стафилококковыми токсинами. Пищевые отравления: Вызваны токсинами, продуцируемыми стафилококком в пище. |
Поддерживающая терапия: Обезболивающие, жаропонижающие, инфузионная терапия при обезвоживании. Симптоматическое лечение: В зависимости от пораженного органа (например, бронхолитики при пневмонии). Пробиотики: Для восстановления микрофлоры после антибиотикотерапии. Вакцинация: В разработке, пока нет широкодоступной вакцины против стафилококка. |
| Осложнения | Антибиотикорезистентность: Развитие устойчивости стафилококка к антибиотикам, что затрудняет лечение. Хронические инфекции: Длительное течение заболевания, рецидивы. Повреждение органов: Необратимые изменения в пораженных органах (например, разрушение суставов, почечная недостаточность). Летальный исход: При тяжелых формах инфекции, особенно при сепсисе и токсическом шоке. |
Мониторинг: Регулярные анализы для оценки эффективности лечения и выявления осложнений. Консультации специалистов: Привлечение инфекционистов, хирургов, кардиологов и других врачей по мере необходимости. Реабилитация: Восстановительные мероприятия после перенесенной инфекции. |
Интересные факты
Вот несколько любопытных фактов о стафилококках и связанных с ними рисках:
-
Разнообразие штаммов: Стафилококки представляют собой группу бактерий, среди которых наиболее известен Staphylococcus aureus. Этот штамм способен вызывать различные инфекции — от незначительных кожных заболеваний до серьезных состояний, таких как пневмония, менингит и сепсис. Некоторые штаммы, например, MRSA (метициллин-резистентный стафилококк), обладают устойчивостью к антибиотикам, что усложняет процесс лечения.
-
Токсины и пищевые отравления: Стафилококки могут выделять токсины, способные вызывать пищевые отравления. Например, стафилококковый энтеротоксин может привести к рвоте и диарее после употребления зараженной пищи, даже если сами бактерии были уничтожены в процессе термической обработки.
-
Лечение и профилактика: Лечение инфекций, вызванных стафилококками, может включать антибиотики, однако важно учитывать устойчивость бактерий. В некоторых случаях может потребоваться хирургическое вмешательство для удаления инфицированных тканей. Профилактика включает соблюдение гигиенических норм, таких как регулярное мытье рук и правильное хранение продуктов питания, что помогает снизить риск заражения.
Эти факты подчеркивают важность осведомленности о стафилококках и необходимость своевременного обращения за медицинской помощью при подозрении на инфекцию.

Вред для организма
Инфекционный агент, проникая в человеческий организм, вызывает воспалительные процессы в различных органах и тканях. Он производит экзотоксины, которые негативно воздействуют на кожные покровы и клетки крови, а также энтеротоксины, способствующие возникновению симптомов пищевого отравления. Кроме того, он выделяет вещества, подавляющие иммунные реакции организма, что позволяет микроорганизмам более активно распространяться.
Когда возбудитель попадает в организм, возникает бактериемия, и начинается воспалительный процесс. Стафилококк, распространяясь по тканям и органам, может поражать внутренние органы человека.
В данном видеоролике специалист подробно объясняет патогенез этого возбудителя и его негативное влияние на организм.
Стафилококк представляет собой группу бактерий, способных вызывать широкий спектр инфекций — от незначительных кожных заболеваний до серьезных состояний, таких как пневмония или сепсис. Часто упоминается, что стафилококк представляет опасность из-за своей способности вызывать гнойные воспаления и устойчивость к антибиотикам, что затрудняет процесс лечения. Инфекции, вызванные золотистым стафилококком, могут проявляться в виде фурункулов, карбункулов и инфекций после операций. Лечение, как правило, включает антибиотики, однако выбор конкретного препарата зависит от чувствительности бактерий. Также важно соблюдать гигиенические нормы и избегать контактов с зараженными, чтобы минимизировать риск распространения инфекции. При появлении таких симптомов, как покраснение, отек или боль, следует незамедлительно обратиться к врачу для диагностики и назначения соответствующего лечения.
Виды и степени поражения стафилококковой инфекции
Стафилококки насчитывают более 27 различных штаммов, из которых около 14-15 считаются нормальными обитателями человеческого организма. Однако существуют четыре типа возбудителей, которые могут нанести серьезный вред и вызвать различные заболевания:
- Золотистый стафилококк – это самый опасный и известный вид. При попадании в организм он способен поражать все системы и органы, вызывая воспалительные процессы. Он устойчив к высоким температурам, спирту и некоторым антибиотикам. Может вызывать такие заболевания, как пневмония, сепсис, остеомиелит, а также кожные инфекции (фурункулы, карбункулы, чирьи, ячмень).
- Эпидермальный стафилококк – представляет опасность для недоношенных детей, людей с ослабленным иммунитетом и онкобольных. Может привести к поражению эндокарда и сепсису. Этот штамм обитает на слизистых оболочках и кожных покровах человека.
- Сапрофитный стафилококк – чаще всего встречается на половых органах женщин и в мочеиспускательном канале. Он может стать причиной цистита и уретрита.
- Гемолитический стафилококк – вызывает инфекции мочевых путей, сепсис, эндокардит и кожные заболевания.
Носительство этих бактерий само по себе не является заболеванием, но может привести к заражению других людей. Факторы, такие как переохлаждение, перенесенные операции, а также частые простудные и вирусные инфекции, могут спровоцировать серьезные проблемы со здоровьем.
В этом видео наглядно демонстрируется, как золотистый стафилококк проникает в человеческий организм и как быстро он размножается.
Существует четыре степени инфицирования стафилококком, каждая из которых характеризуется различной тяжестью и симптомами. Понимание степени поражения помогает определить подходы к лечению и прогноз заболевания.
1 степень – при хорошем иммунитете симптомы отсутствуют, и лечение не требуется.
2 степень – обычно лечение не назначается, но могут потребоваться дополнительные обследования на наличие сопутствующих инфекций. Врач определяет тактику дальнейших действий.
3 степень – при обнаружении стафилококков на этом уровне врачи, как правило, назначают антибактериальную терапию. При сбоях в организме начинается воспалительный процесс.
4 степень – выраженная патология. После определения чувствительности к конкретным препаратам требуется специфическое лечение.
https://youtube.com/watch?v=rkS63L84oik
Симптомы
Симптоматика стафилококковой инфекции варьируется в зависимости от места, где происходит проникновение и размножение бактерий, а также от штамма и его агрессивности.
Инкубационный период может длиться от нескольких часов до 10-12 дней. Общие признаки стафилококковой инфекции могут включать:
- повышение температуры;
- покраснение и зуд кожи;
- кашель, насморк, чихание, выделение мокроты;
- симптомы пищевого отравления;
- отечность и покраснение горла, ушей и ротовой полости.
Специфические симптомы зависят от того, какой орган подвергся воздействию инфекции.
- Пиодермия – это поражение кожи с образованием гноя. Бактерия проникает через порезы и ссадины, вызывая воспаление. К основным проявлениям кожных заболеваний относятся:
- Фурункул – гнойное воспаление, чаще всего в области волосяных фолликулов и сальных желез.
- Карбункул – воспаление кожи и подкожной клетчатки с образованием гноя.
- Гидраденит – воспаление потовых желез.
- Фолликулит – воспаление волосяных мешочков, в основном верхних, с образованием гнойничка в центре.
- Заболевания дыхательных путей
- Ринит – воспаление слизистой носа, проявляющееся обильным выделением слизи, ухудшением обоняния и затруднением дыхания.
- Фарингит – воспаление слизистой глотки, сопровождающееся кашлем, сухостью и дискомфортом в горле, особенно при глотании, а также накоплением слизи.
- Ларингит – воспаление слизистой гортани, проявляющееся изменением голоса или его потерей, болью в горле и незначительным повышением температуры.
- Синусит – воспаление придаточных пазух носа, проявляющееся болями в области пазух, повышением температуры, гнусавостью голоса, общей слабостью и насморком с желто-зелеными выделениями.
- Бронхит – воспаление бронхов, характеризующееся сильным кашлем с выделением мокроты или без него, одышкой и болями в груди.
-
Заболевания пищеварительного тракта – бактериальный стоматит, энтероколит, холецистит. Симптомы могут включать рвоту, диарею, колики, тошноту, изжогу и появление язвочек в ротовой полости.
-
Заболевания мочеполовой системы – цистит, уретрит, пиелонефрит.
Стафилококковая инфекция встречается примерно в 10% случаев в гинекологии. В этом случае возбудитель вызывает воспаление слизистой матки, влагалища и мочеиспускательного канала. Симптомы включают гнойные выделения, боли внизу живота, нарушения менструального цикла и болезненное, частое мочеиспускание с ощущением жжения.
-
Заболевания центральной нервной системы – менингит, абсцесс. Эти состояния представляют серьезную угрозу для жизни, сложно поддаются лечению и могут оставить негативные последствия для здоровья.
-
Заболевания сердечно-сосудистой системы – эндокардит, перикардит.
Некоторые штаммы стафилококка могут вызывать воспаление сердечных тканей. При отсутствии своевременного лечения возможен летальный исход.
Диагностика
В зависимости от проявления определенных симптомов, следует обратиться к таким специалистам, как дерматолог, отоларинголог или инфекционист.
Когда стафилококковая инфекция проявляется через кожные поражения, как правило, не требуется проведение сложных обследований. Визуальный осмотр воспалительных участков позволяет установить диагноз. Однако в сочетании с другими симптомами могут понадобиться дополнительные диагностические процедуры.
Для диагностики данной инфекции у пациента собирается анамнез, который включает жалобы, информацию о контактах с инфицированными людьми, а также сведения о недавних заболеваниях и принимаемых медикаментах.
При осмотре можно заметить покраснение кожи, наличие гнойничковых образований, которые выступают над поверхностью кожи, гиперемию зева и налет на миндалинах.
Лабораторные исследования могут включать анализы крови, мочи, кала, грудного молока, содержимого гнойников, а также мазок из зева. У женщин, испытывающих гинекологические проблемы, дополнительно берется мазок из влагалища.
Лечение
После того как был установлен штамм стафилококка, а также определены степень поражения и место его локализации, врач подбирает оптимальный курс лечения.
При легких формах заболевания возможно использование симптоматической терапии.
В случае тяжелых форм поражения применяются следующие методы:
- Антибактериальная терапия – амоксициллин, ванкомицин, оксациллин, цефазоллин, эритромицин.
- Препараты против стафилококка – стафилококковый бактериофаг, стафилококковый анатоксин, иммуноглобулин.
- Хирургические вмешательства – фурункулы, чирьи и гнойнички удаляются оперативным путем с использованием местной анестезии.
- Иммуномодуляторы – бронхомунал, иммудон.
- Витаминотерапия.
- Симптоматическая терапия.
Перед началом антибактериальной терапии обязательно необходимо провести антибиотикограмму, чтобы определить устойчивость к конкретным препаратам.
Народные средства:
- Хлорофиллипт – используется для лечения ЛОР и кожных заболеваний. Спиртовой раствор подходит для полоскания горла и промывания носа, масляный – для закапывания в нос. Пораженные участки кожи обрабатываются тампоном, смоченным в масляном растворе.
- Яблочный уксус – применяется для лечения кожных повреждений. Для этого рекомендуется принимать ванны с добавлением 50 граммов уксуса. Продолжительность процедур составляет 15-20 минут несколько раз в день.
- Лопух – листья промываются и прикладываются к пораженным участкам кожи. Обладает заживляющим и антибактериальным эффектом.
- Мед с клюквой. Смешайте 100 граммов меда со стаканом клюквы и дайте настояться час в холодильнике. Первую порцию следует съесть утром натощак, а остальное – в течение дня. Курс лечения продолжается 2 недели.
- Фруктовое пюре. Пюре из абрикоса или черной смородины рекомендуется употреблять на голодный желудок по одному стакану три раза в день.
- Сухой зверобой. Заварите 2 чайные ложки травы стаканом кипятка, накройте тканью и дайте настояться 30 минут. Принимайте на голодный желудок перед завтраком и ужином.
Особенности протекания и тактика лечения инфекции у новорожденных и детей
Новорожденные дети нередко становятся носителями стафилококка уже в роддоме. Основным источником инфекции могут быть грудное молоко матери или зараженный медицинский персонал. У малышей иммунная система еще не полностью сформирована, что делает их уязвимыми к воздействию патогенных микроорганизмов.
Симптомы стафилококковой инфекции у младенцев могут проявляться в виде: резкого повышения температуры, насморка, вялости, капризов, диареи, рвоты и покраснения области пупка. В дальнейшем эти признаки могут развиться в более серьезные заболевания.
Стафилококковая инфекция представляет собой серьезную угрозу для здоровья детей и может закончиться летальным исходом. Поэтому при выявлении инфекции малыши должны быть немедленно госпитализированы для проведения необходимого симптоматического и антибактериального лечения.
Особенности протекания и лечения стафилококковой инфекции у беременных
Во время беременности у женщин наблюдается ослабление иммунной системы, что делает их более уязвимыми к различным инфекциям. Одним из распространенных возбудителей является стафилококк, который может вызывать разнообразные симптомы.
Инфекция может проявляться как местными, так и общими реакциями. К местным симптомам относятся:
- поражения кожи (фурункулы, карбункулы);
- поражения слизистых оболочек (конъюнктивит, ринит, вульвовагинит);
- поражения дыхательных путей (ангина, тонзиллит, ларингит).
Общая инфекция, как правило, протекает более тяжело и представляет большую опасность для здоровья беременной женщины.
Существует две стадии течения инфекции:
- септицемия – микробы попадают в кровоток, вызывая выраженные симптомы заражения;
- септикопиемия – возбудитель размножается в крови, приводя к образованию вторичных гнойных очагов в организме.
Эти процессы могут серьезно угрожать развитию плода. Инфицирование крови стафилококком у беременных может привести к следующим последствиям:
- резкому снижению артериального давления, что может вызвать гипоксию плода;
- инфицированию плодных оболочек;
- перитониту;
- попаданию инфекции в грудное молоко.
Лечение инфекций у беременных должно быть комплексным и учитывать противопоказания многих медикаментов. Поскольку применение антибиотиков в этот период нежелательно, врач должен тщательно оценить состояние пациентки и возможные риски для здоровья как женщины, так и плода. На основе этой оценки принимается решение о методах лечения. Для профилактики инфицирования плода беременным рекомендуется проводить иммунизацию стафилококковым анатоксином.
Осложнения и последствия
Стафилококковая инфекция способна вызвать крайне серьезные последствия. Этот патогенный микроорганизм, проникая в кровоток, может затрагивать важнейшие органы, такие как сердце, головной мозг и почки. При распространении по организму может развиться сепсис.
Если лечение стафилококковой инфекции не начато вовремя, это может привести к осложнениям, таким как эндокардит, сепсис, менингит и инфекционно-токсический шок.
Профилактика
Предотвратить заболевание гораздо проще, чем его лечить. Следуя нескольким простым рекомендациям, вы значительно снизите риск попадания инфекции в организм:
- своевременное устранение воспалительных процессов (воспаленные миндалины и аденоиды, ячмени, конъюнктивиты, блефариты, кариес);
- соблюдение правил личной гигиены;
- проведение профилактических мероприятий против гриппа, ОРВИ и простуд;
- укрепление иммунной системы (занятия спортом, отказ от вредных привычек, сбалансированное питание);
- употребление тщательно вымытых и качественных продуктов;
- поддержание чистоты в доме, стирка белья и вещей, а также регулярное проветривание помещений;
- обращение к врачу при первых признаках возможного инфицирования.
Изолироваться от общества и патогенных бактерий, которые в нем обитают, невозможно. Не стоит паниковать, если ваш организм столкнулся с таким возбудителем, как стафилококк. Своевременное обращение к специалисту, правильно подобранная схема лечения и регулярная профилактика помогут вам избавиться от этого недуга без вреда для здоровья.
Рекомендации по уходу за пациентами с стафилококковой инфекцией
Уход за пациентами, страдающими от стафилококковой инфекции, требует особого внимания и соблюдения определенных рекомендаций, чтобы минимизировать риск распространения инфекции и обеспечить эффективное лечение. Следует учитывать, что стафилококки могут вызывать широкий спектр заболеваний, начиная от незначительных кожных инфекций и заканчивая серьезными системными состояниями, такими как пневмония или сепсис.
1. Соблюдение гигиенических стандартов: Ключевым элементом ухода за пациентами с стафилококковой инфекцией является строгая личная гигиена. Регулярное мытье рук с мылом и применение антисептиков помогут предотвратить передачу инфекции. Медицинский персонал и близкие должны тщательно мыть руки до и после контакта с пациентом, а также после обработки ран или смены повязок.
2. Уход за ранами: Если у пациента есть открытые раны или абсцессы, их необходимо регулярно обрабатывать. Рекомендуется использовать стерильные повязки и антисептики, такие как хлоргексидин или перекись водорода. Важно следить за состоянием раны, чтобы вовремя заметить признаки инфекции, такие как покраснение, отек или гнойные выделения.
3. Изоляция пациента: В случае тяжелых форм стафилококковой инфекции, особенно если она вызвана метициллин-резистентным стафилококком (MRSA), пациенту может потребоваться изоляция. Это поможет предотвратить распространение инфекции на других пациентов и медицинский персонал. Изоляция должна строго соблюдаться до тех пор, пока пациент не станет не заразным.
4. Создание комфортных условий: Пациенты с инфекцией могут испытывать дискомфорт и боль. Обеспечение комфортной температуры в помещении, использование мягкой постели и подушек, а также регулярное изменение положения тела помогут улучшить самочувствие пациента. Также важно следить за достаточным потреблением жидкости и питательных веществ.
5. Мониторинг симптомов: Необходимо внимательно следить за состоянием пациента и обращать внимание на любые изменения в его самочувствии. Важно фиксировать температуру тела, уровень боли и другие симптомы, чтобы своевременно сообщить врачу о возможном ухудшении состояния.
6. Соблюдение режима лечения: Пациенты должны строго следовать указаниям врача, включая прием антибиотиков и других назначенных препаратов. Важно завершить курс лечения, даже если симптомы исчезли, чтобы предотвратить рецидив инфекции и развитие устойчивости к антибиотикам.
7. Обучение близких: Родственники и опекуны пациентов должны быть обучены основам ухода за больными, включая правила гигиены, обработку ран и распознавание признаков ухудшения состояния. Это поможет создать безопасную среду для пациента и снизить риск передачи инфекции.
Соблюдение этих рекомендаций не только улучшит уход за пациентами с стафилококковой инфекцией, но и поможет предотвратить распространение инфекции в медицинских учреждениях и домашних условиях. Важно помнить, что раннее обращение за медицинской помощью и соблюдение всех предписаний врача являются ключевыми факторами в успешном лечении стафилококковых инфекций.
Советы по укреплению иммунной системы
Укрепление иммунной системы является важным аспектом профилактики инфекций, включая стафилококковые. Существует множество способов, которые могут помочь повысить защитные функции организма и снизить риск заражения. Рассмотрим основные из них.
Правильное питание
Сбалансированное питание играет ключевую роль в поддержании иммунной системы. Включение в рацион разнообразных продуктов, богатых витаминами и минералами, поможет организму эффективно бороться с инфекциями. Витамины A, C, D и E, а также минералы, такие как цинк и селен, способствуют укреплению иммунитета. Рекомендуется употреблять:
- Фрукты и овощи, особенно цитрусовые, ягоды, брокколи и шпинат.
- Цельнозерновые продукты, такие как овсянка и коричневый рис.
- Белковые продукты, включая нежирное мясо, рыбу, яйца и бобовые.
- Полезные жиры, например, оливковое масло и орехи.
Физическая активность
Регулярные физические нагрузки способствуют улучшению кровообращения и повышению общего тонуса организма. Умеренные физические упражнения, такие как ходьба, плавание или йога, могут помочь укрепить иммунную систему. Рекомендуется заниматься физической активностью не менее 150 минут в неделю.
Сон и отдых
Качественный сон необходим для восстановления организма и поддержания иммунной функции. Хроническое недосыпание может ослабить иммунитет и сделать организм более уязвимым к инфекциям. Взрослым рекомендуется спать не менее 7-8 часов в сутки. Также важно уделять время отдыху и расслаблению, чтобы снизить уровень стресса.
Управление стрессом
Хронический стресс негативно влияет на иммунную систему, поэтому важно находить способы его управления. Практики, такие как медитация, глубокое дыхание, йога и занятия хобби, могут помочь снизить уровень стресса и улучшить общее самочувствие.
Отказ от вредных привычек
Курение и чрезмерное употребление алкоголя могут ослабить иммунную систему. Отказ от этих привычек поможет улучшить здоровье и повысить защитные функции организма. Если у вас есть трудности с отказом от вредных привычек, стоит обратиться за помощью к специалистам.
Регулярные медицинские обследования
Профилактические медицинские осмотры и вакцинация могут помочь предотвратить многие инфекции. Обсуждение с врачом необходимых прививок и регулярное обследование на наличие хронических заболеваний помогут поддерживать здоровье на высоком уровне.
Следуя этим рекомендациям, вы сможете значительно укрепить свою иммунную систему и снизить риск заражения стафилококком и другими инфекциями. Помните, что здоровье — это комплексный подход, включающий в себя правильное питание, физическую активность, управление стрессом и регулярные медицинские проверки.
Вопрос-ответ
Как вывести стафилококк из организма?
Для лечения стафилококковой инфекции применяют антибиотики нового поколения — полусинтетические пенициллины, аминогликозиды и некоторые другие. Также используют бактериофаги — специфические вирусы, которые прицельно уничтожают именно стафилококки.
Как понять, что у тебя стафилококк?
Чтобы понять, что у вас стафилококковая инфекция, обратите внимание на симптомы, такие как покраснение, отек, боль в области поражения, гнойные выделения, а также общее недомогание, повышение температуры и возможные кожные высыпания. Для точной диагностики необходимо обратиться к врачу, который может назначить анализы, такие как посев из пораженной области или анализ крови.
Чем страшен стафилококк?
Чем опасен золотистый стафилококк? В тяжелых случаях может развиться сепсис. Появляется лихорадка с ознобами, гнойные очаги в различных органах, учащенное сердцебиение, снижение артериального давления, увеличение печени и селезенки.
Стафилококк лечится или нет?
Для лечения стафилококковой инфекции используют препараты следующих групп: местные антисептики, которые применяют для лечения и профилактики поверхностных стафилококковых инфекций; антибиотики используют локально, перорально, внутривенно.
Советы
СОВЕТ №1
Регулярно мойте руки с мылом, особенно перед едой и после посещения общественных мест. Это поможет снизить риск заражения стафилококком и другими инфекциями.
СОВЕТ №2
Следите за состоянием своей кожи. При появлении ран, порезов или сыпи обрабатывайте их антисептиками и при необходимости закрывайте повязкой, чтобы предотвратить попадание бактерий.
СОВЕТ №3
Не занимайтесь самолечением. При подозрении на инфекцию, вызванную стафилококком, обращайтесь к врачу для получения правильного диагноза и назначения адекватного лечения.
СОВЕТ №4
Избегайте контакта с людьми, у которых есть открытые раны или инфекционные заболевания, и не делитесь личными предметами, такими как полотенца или бритвы, чтобы минимизировать риск передачи бактерий.